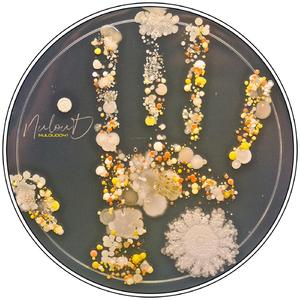
Treponema

Black Rose (Original Mix)
Jonathan Jaramilo

Black Rose (Original Mix)
Jonathan Jaramilo

Extinct (Original Mix)
Jonathan Jaramilo, Mad Raf

Meno Es Mas (Original Mix)
Jonathan Jaramilo & Diego Quintero, Jonathan Jaramilo, Diego Quintero

Meno Es Mas (Original Mix)
Jonathan Jaramilo & Diego Quintero, Jonathan Jaramilo, Diego Quintero

Hunting Humans (Original Mix)
Jonathan Jaramilo

A Way (Jonathan Jaramilo Remix)
Vasco S

A Way (Jonathan Jaramilo Remix)
Vasco S

A Way (Jonathan Jaramilo Remix)
Vasco S

Magenta (Original Mix)
Jonathan Jaramillo, Nathan Bass

Feel the Rythm (Original Mix)
Jonathan Jaramillo

Slang (Original Mix)
Jonathan Jaramillo

She Is (Original Mix)
Jonathan Jaramillo

Who is This
Jonathan Jaramillo

Back In The Game (Original Mix)
Jonathan Jaramillo
Treponema
Jonathan Jaramillo

Stappler (Original Mix)
Jonathan Jaramillo, Nathan Bass

Raquel (Fory Remix)
Jonathan Jaramillo

Freedom (Original Mix)
Jonathan Jaramillo

I know u like it
Jonathan Jaramillo

No Tuned (Original Mix)
Jonathan Jaramillo

Funk With Me
Jonathan Jaramillo

La Odisea (Original Mix)
Jonathan Jaramillo, Nathan Bass

What are you talking about
Jonathan Jaramillo

Izcalli (Original Mix)
Jonathan Jaramillo

Thx Ma
Jonathan Jaramillo

Analogue (Original Mix)
Jonathan Jaramillo

Corpus (Original Mix)
Jonathan Jaramillo, Bryan Kush

Algunas Veces (Original Mix)
Jonathan Jaramillo, Bryan Kush

Hoo (Original Mix)
Jonathan Jaramillo

Imaginary Boy (Original Mix)
Jonathan Jaramillo

Raquel
Jonathan Jaramillo

Keep Moving
Jonathan Jaramillo, Steve Aguirre

Gimme the Bottle
Jonathan Jaramillo, Victor Vergara

Good Enough
Jonathan Jaramillo, Fenky

Caralho
Jonathan Jaramillo, J Aristi

Do 2 Do
Jonathan Jaramillo, GAGH

La Trevesia (Original Mix)
Jonathan Jaramillo, Nathan Bass

Bailalo
Jonathan Jaramillo, SONO (COL)

Mambo (Original Mix)
Jonathan Jaramillo

Siembra (Original Mix)
Jonathan Jaramillo

Fake Fake (Original Mix)
Jonathan Jaramillo

Besame (Original Mix)
Jonathan Jaramillo

Bad Me (Original Mix)
Jonathan Jaramillo, Minijack

Monalisa
Jonathan Jaramillo, Joonyes

Straight
Jonathan Jaramillo, Joonyes

Headline (Original Mix)
Jonathan Jaramillo, Arthur Ferrèyra

Strike (Original Mix)
Jonathan Jaramillo

Gang
Jonathan Jaramillo, Juan de la Torre

Got a Work
Jonathan Jaramillo, Andres Losada

Be Close Up (Original Mix)
Jonathan Jaramillo, Flaminik

Drum Killah
Jonathan Jaramillo

Lluvia con Nieve
Jonathan Jaramillo

Blaster (Original Mix)
Jonathan Jaramillo, Nathan Bass

No **** no *** (Original Mix)
Jonathan Jaramillo, Nathan Bass

Igor (Original Mix)
Jonathan Jaramillo, Nathan Bass